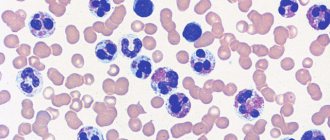

The disease pelvic thrombophlebitis is inflammatory changes in the venous wall, accompanied by the formation of a blood clot. Defeat
1 Author of the article: Marina Dmitrievna 2017.08.05 16 103 Leukocytes Basophil and eosinophil are
Symptoms of increased tone in infants Increased tone in infants is diagnosed quite easily - not
The human body is characterized by thrombosis of veins in the lower extremities. Can overlap superficial or deep
The relationship between hypertension and hypothyroidism When the function of the thyroid gland is low, the formation of its hormones decreases -
Extrapleural access Penetrate into the mediastinum through the interpleural field. Technique. Longitudinal dissection of the sternum throughout
Author's rating Author of the article Elena Stanislavovna Zelenaya Otolaryngologist of the second category Articles written 665
What is cholesterol? Cholesterol is the main link in lipid (fat) metabolism. More synthesized
Medical certificate Diabetes mellitus is a disease in which there is an increased level of sugar in the
Description of the pathology When the sinus node is weakened or stops working, and this happens either